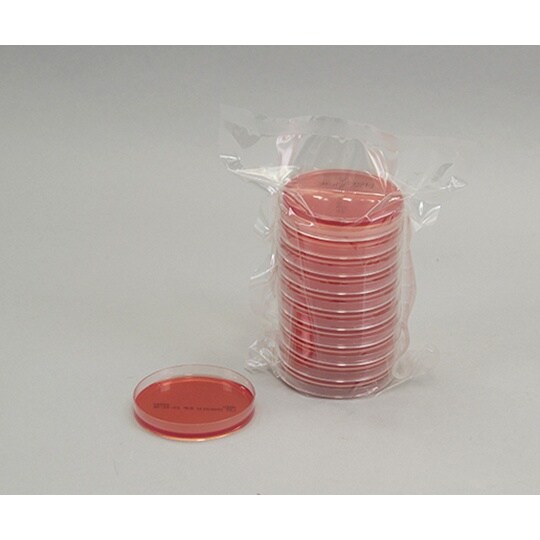
【冷蔵】生培地 卵黄加マンニット食塩寒天20枚入

アズワン
【冷蔵】生培地 卵黄加マンニット食塩寒天20枚入 04103 培地関連用品 1箱
【9156-2654】



| ¥3,135 (税込) / ¥2,850 (税抜) |
| ¥3,135 (税込) / ¥2,850 (税抜) |
| メーカー希望小売価格※税抜 (割引率) ¥3,000(5%) |
|---|
培地関連用品の売れ筋ランキング
- ¥6,030(税込) (税込)
- ¥3,135(税込) (税込)
- ¥2,090(税込) (税込)
商品の特徴 |
培地調製の手間が省け、すぐお使いいただけます。細菌検査の初心者から熟練者の方まで幅広くお使いいただけます。今まで平板培地の作成に必要だった培地の調製・器具の洗浄・粉末培地・試薬等の在庫管理を行う必要が |
|---|---|
商品仕様 |
|
メーカー情報 |
|
カタログ掲載ページ |
-/- |
| 注意事項 | ※【お届けに関するご注意】この商品は、画面に表示されているお届け予定日までにお届けいたします。実際のお届けが、予定日よりも早まる場合がございます。【返品に関するご注意】この商品は直送品のため、お客様のご都合による返品はお受けできません。 |
|---|